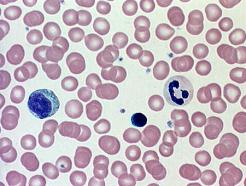
11.jpg

Vai salīdzinoši liela eritrocītu virsma attiecībā pret šūnas tilpumu ir pielāgojums veicamajai funkcijai?
Lai iesniegtu atbildi un redzētu rezultātus, Tev nepieciešams autorizēties. Lūdzu, ielogojies savā profilā vai reģistrējies portālā!